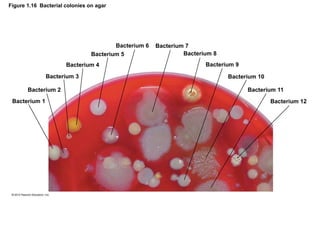
Figure 1.16 Bacterial colonies on agar
Bacterium 1
Bacterium 2
Bacterium 3
Bacterium 4
Bacterium 5
Bacterium 6 Bacterium 7
Bacterium 8
Bacterium 9
Bacterium 10
Bacterium 11
Bacterium 12
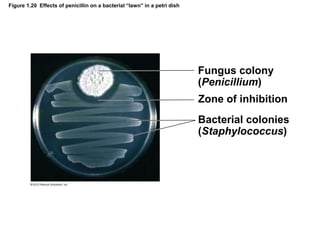
Figure 1.20 Effects of penicillin on a bacterial “lawn” in a petri dish
Fungus colony
(Penicillium)
Zone of inhibition
Bacterial colonies
(Staphylococcus)

This document provides an overview of the history of microbiology from its early beginnings with Anton van Leeuwenhoek's microscopic observations of microorganisms in the 1670s through the modern age of microbiology. It summarizes key findings and contributors such as Pasteur disproving spontaneous generation; Koch establishing methods to prove microbes cause specific diseases; and advances in biochemistry, genetics, and molecular biology that have allowed manipulation of microbes for applications like gene therapy and bioremediation. The document emphasizes how microbiology has advanced through applying the scientific method to answer questions about microbes, disease, and their uses in industry and the environment.